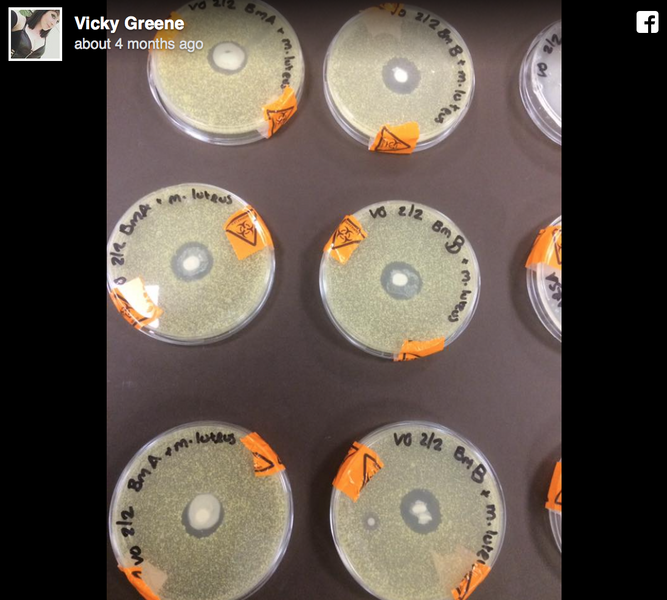

Revolutionizing Postpartum Blog
The Amazing Benefits of Cord Blood Banking
Thank you to the team at Progenics Cord Blood Cryobank for sharing what-you-need-to-know including what is Cord Blood, what are the benefits of cord Blood Banking, and more. Read to the end to learn more about Progenics and for a special NAKEDTANK discount.
As expecting parents, you want the very best for your baby, ensuring their health and well-being from the get-go. One incredible way to safeguard their future health is by considering cord blood banking.
How A Postpartum Doula Can Support Your Breastfeeding Journey
Sherri Phillips, founder of Baby Helping Hands, shares how a Postpartum Doula can support your breastfeeding journey. Enjoy!
The latest MUST-HAVE for an expecting mother: The New Mama Celebration Planner
Hello mamas!
It’s time to revolutionize baby shower etiquette by adding in New Mommy must-haves that support you as you prepare for motherhood. Whe...
Are Inverted Nipples Normal?
"If you're born with inverted nipples, it's usually just a genetic difference in how your nipples were made, and is very rarely a problem even with breastfeeding," confirms Mary Claire Haver, M.D., an ob-gyn at the University of Texas Medical Branch. --Shape Magazine online
13 Beautiful Tandem Breastfeeding Photos
By Nicole Fabian-Weber
Ask any mom and she'll tell you: Although breastfeeding is as natural as it gets, it can be hard. So, imagine doing...
WHY THIS IMAGE OF BREAST MILK IN A PETRI DISH IS BLOWING UP THE INTERNET’S MIND
The perimeter of each Petri dish is filled with bacteria; but in the center, where the breast milk was placed, the bacteria is completely gone, killed off by the breast milk.
Pope Francis proves once again that he has breastfeeding moms' backs
“You mothers, go ahead and breastfeed, without fear. Just like the Virgin Mary nursed Jesus.”